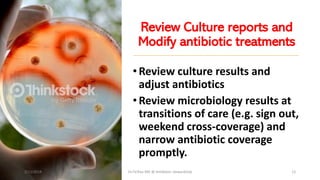
Review Culture reports and
Modify antibiotic treatments
•Review culture results and
adjust antibiotics
•Review microbiology results at
transitions of care (e.g. sign out,
weekend cross-coverage) and
narrow antibiotic coverage
promptly.
2/11/2019 Dr.T.V.Rao MD @ Antibiotic stewardship 12

The document discusses antibiotic stewardship and strategies to combat antibiotic resistance. It outlines how inappropriate antibiotic use has led to increased antibiotic resistant organisms and how antimicrobial stewardship aims to optimize antibiotic use and minimize unintended consequences. The document provides numerous examples of antibiotic stewardship strategies including obtaining cultures before prescribing antibiotics, using local antibiotic resistance data to guide treatment, reviewing culture results to modify prescriptions, restricting broad-spectrum antibiotics, and monitoring treatment response and duration. It stresses the importance of education, guidelines, surveillance, and metrics to evaluate antibiotic stewardship programs.